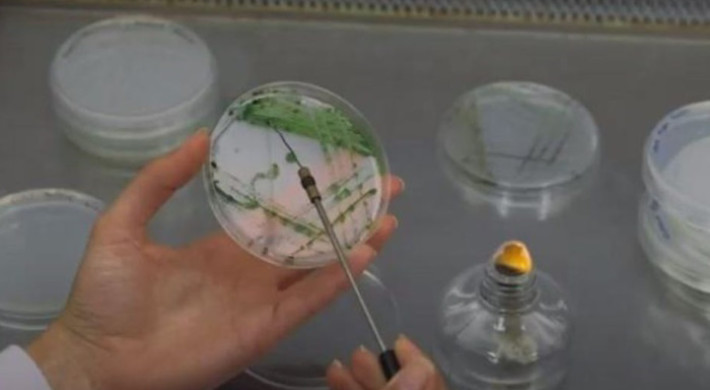

Na região do Algarve, o investimento em investigação e desenvolvimento (I&D) atingiu os 54 milhões de euros (M€) no ano de 2022, segundo dados agora divulgados pela Direção-Geral de Estatísticas da Educação e Ciência (DGEEC).
Segundo o relatório IPCTN22: Investigação e Desenvolvimento (I&D): principais indicadores por região, ontem publicado, o investimento em I&D no Algarve representa 0,47% do Produto Interno Bruto (PIB) gerado na região, (54 M€), o valor mais elevado dos últimos anos.
Em 2019, o investimento em I&D foi de 41 milhões de euros, 0,41 % em percentagem do PIB regional representando as empresas 0,11%. Em 2022, o investimento consolidado em I&D atingiu os 54 M€, os referidos 0,47% do PIB gerado na região.
Também ao nível do pessoal e investigadores em I&D regista-se um acréscimo, com 1,157,9 Equivalente e Tempo Integral (ETI), correspondendo a 5,2% da população ativa, no ano de 2022, por comparação com os 1.044,4 ETI, 4,7% da população ativa, no ano de 2021.
Para José Apolinário, Presidente da Comissão de Coordenação e Desenvolvimento Regional (CCDR) do ALGARVE e da Autoridade de Gestão do Programa Regional ALGARVE 2030, “é necessário reforçar o investimento em investigação e desenvolvimento na região, em especial na transferência de conhecimento para e com as empresas, juntando as diversas entidades, com papel chave da Universidade do Algarve, dos Laboratórios associados e colaborativos, das áreas do mar, saúde e desenvolvimento sustentável, reforçando também o papel da Dieta Mediterrânica, visando superar os 60 milhões de euros em investimento I&D ainda no ano de 2024”.